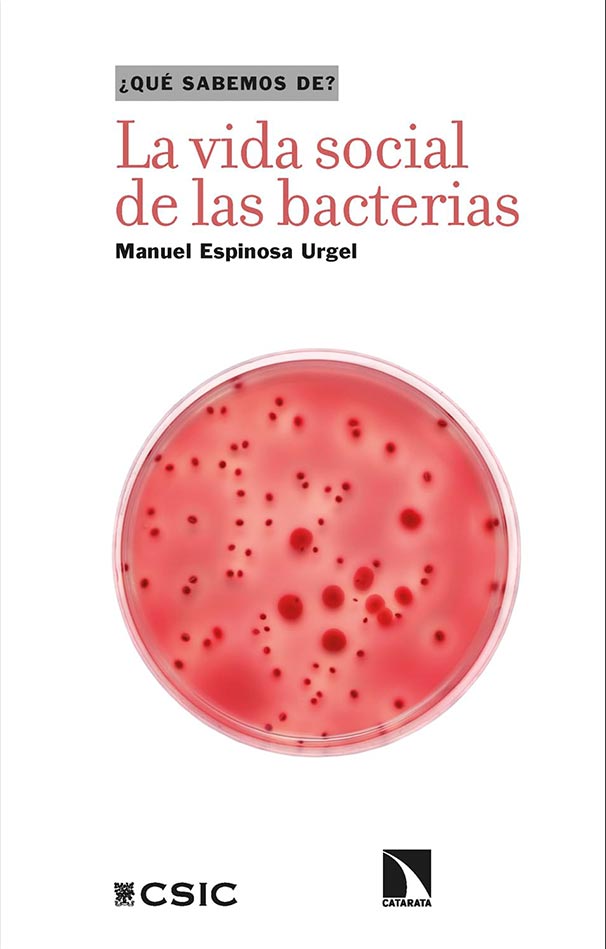

LA VIDA SOCIAL DE LAS BACTERIAS
ISBN: 9788410671676
AUTORES: MANUEL ESPINOSA URGEL
Sinopsis
Las bacterias parecen comunicarse entre sí y su vida social influye notablemente sobre nuestra propia vida.
Hasta hace un par de décadas, la visión más extendida de las bacterias era la de organismos unicelulares relativamente simples, cuya vida consistía en aprovechar individualmente los nutrientes disponibles para multiplicarse y, en algunos casos, causar infecciones. Nada más lejos de la realidad. Hoy sabemos que las bacterias cuentan con un amplio y complejo repertorio de herramientas que les permiten sobrevivir en hábitats muy diversos, hasta en ambientes casi imposibles para otras formas de vida. Una de las principales estrategias de persistencia es precisamente pasar del estilo de vida libre unicelular a la formación de comunidades multicelulares asociadas a superficies y rodeadas de una envuelta protectora, la biopelícula, responsable de infecciones crónicas y de favorecer la resistencia frente a antibióticos. Además, las bacterias pueden comunicarse entre sí y con otros microorganismos. Estos descubrimientos ofrecen una perspectiva diferente de las bacterias, mostrándolas como seres sociales, y además, la vida social de las bacterias influye notablemente sobre nuestra propia vida.
$28,000.00 El precio original era: $28,000.00.$25,200.00El precio actual es: $25,200.00.
$28,000.00 El precio original era: $28,000.00.$25,200.00El precio actual es: $25,200.00.
Sin existencias
| Peso | 0.182 kg |
|---|---|
| Dimensiones | 1 × 13.5 × 21 cm |
| ISBN | 9788410671676 |
| Ilustradores | |
| Sello | CATARATA |
| Páginas | 162 |
| Idioma | ESPAÑOL |
Otros libros similares
-
BEBIDAS PARA LAS 4 ESTACIONES
Save10%Save $2,390.00Only$21,510.00$23,900.00El precio original era: $23,900.00.$21,510.00El precio actual es: $21,510.00. -
JUANA BIARNES
Save10%Save $3,420.00Only$30,780.00$34,200.00El precio original era: $34,200.00.$30,780.00El precio actual es: $30,780.00. -
FOTOGRAFIA Y VIDEO DIGITAL
Save10%Save $4,310.00Only$38,790.00$43,100.00El precio original era: $43,100.00.$38,790.00El precio actual es: $38,790.00. -
AREQUIPA EN BLANCO Y NEGRO
Save10%Save $3,660.00Only$32,940.00$36,600.00El precio original era: $36,600.00.$32,940.00El precio actual es: $32,940.00.